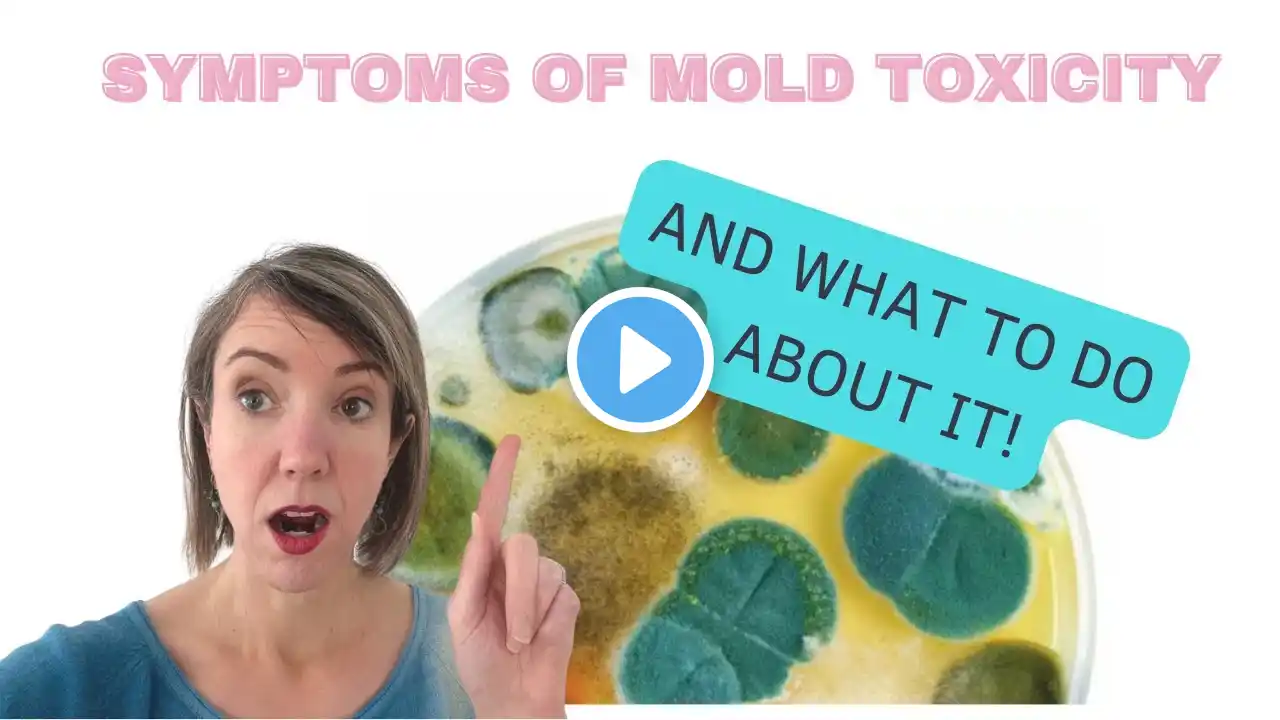
ภาพตัวอย่างวิดีโอ

Mold Toxicity | 9 Symptoms of Mold Toxicity | Dr. J9 Live
Mold Toxicity | 9 Symptoms of Mold Toxicity | Dr. J9 Live In this video Dr. Janine shares 9 symptoms of mold toxicity. She talks about allergic reactions like sinus congestion and chronic coughs. She explains brain function symptoms of mold toxicity like headaches, and light sensitivity. She looks and muscle and joint symptoms of mold toxicity like fatigue and weakness, as well as morning stiffness and joint pain. She explains how digestive issues can be symptoms of mold toxicity. Dr. Janine talks about appetite reactions as symptoms of mold toxicity, like appetite swings or a metallic taste in the mouth. She explains how having difficulty regulating body temperature could be a symptom of mold toxicity. She looks at how static shocks could be a symptom of mold toxicity. She talks about for frequent infections could be a symptom of frequent infections. Lastly Dr. Janine talks about how having chemical sensitivities could also be a symptom of mold toxicity. Video Chapters 00:00 – Intro 00:11 – Somethings You Wouldn’t Expect 01:20 – Symptom #1 Allergic Reactions 02:30 – Symptom #2 Brain Function 03:05 – Symptom #3 Muscle & Joint Function 03:40 – Symptom #4 Digestive Issues 04:10 – Symptom #5 Appetite Reactions 04:54 – Symptom #6 Body Temperature Swings 05:07 – Symptom #7 Static Shocks 05:47 – Symptom #8 Frequent Infections 06:17 – Symptom #9 Multiple Chemical Sensitivities Watch the Dr. Janine Show -Online every Tuesday 12pm ETS -And chat with Dr. Janine live during the show. Connection with Doctor Janine: Instagram: / doctorjanine Facebook: / drj9live Twitter: https://twitter.com/drj9live?lang=en Tik Tok: https://www.tiktok.com/@j9naturally?l... YouTube: / vitatree Pinterest: https://www.pinterest.ca/drj9live #mold #moldtoxicity #toxicmold